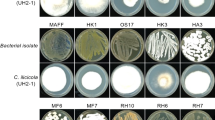

Abstract
Basal stem rot due to a fungal pathogen, Ganoderma boninense, is one of the most devastating diseases in oil palm throughout the major palm oil producer countries. This study investigated the potential of polypore fungi as biological control agents against pathogenic G. boninense in oil palm. In vitro antagonistic screening of selected non-pathogenic polypore fungi was performed. Based on in planta fungi inoculation on oil palm seedlings, eight of the 21 fungi isolates tested (GL01, GL01, RDC06, RDC24, SRP11, SRP12, SRP17, and SRP18) were non-pathogenic. In vitro antagonistic assays against G. boninense revealed that the percentage inhibition of radial growth (PIRG) in dual culture assay for SRP11 (69.7%), SRP17 (67.3%), and SRP18 (72.7%) was relatively high. Percentage inhibition of diameter growth (PIDG) in volatile organic compounds (VOCs) in dual plate assay of SRP11, SRP17, and SRP18 isolates were 43.2%, 51.6%, and 52.1%, respectively. Molecular identification using the internal transcribed spacer gene sequences of SRP11, SRP17, and SRP18 isolates revealed that they were Fomes sp., Trametes elegans, and Trametes lactinea, respectively.
Similar content being viewed by others
Introduction
The African oil palm (Elaeis guineensis Jacq.) is an oil-producing crop cultivated primarily in tropical regions, especially in Indonesia and Malaysia, constituting 60% and 25% of the global vegetable oil supplies, respectively1. However, the large-scale cultivation of oil palm is seriously threatened by basal stem rot disease (BSR), a devastating disease mainly caused by Ganoderma boninense, a phytopathogen basidiomycete fungus2,3. Infected plants usually rot at the palm stem base, collapse, and eventually die. Basal stem rot infections has resulted in significant yield loss due to a reduction in the number of standing oil palm trees per hectare and productivity of the fresh fruit bunches4,5. Based on a study in three oil palm plantations located in Sabah, Malaysia, it was estimated that the yield loss due to the disease can be up to 68.73% in 12 months, which is estimated to be an average of USD4112.78 per year6.
To date, effective prophylactic and curative treatments are not yet available for the disease. Nevertheless, integrated disease management is highly recommended to minimise the economic loss through disease control methods, such as the use of biological control agents (BCAs), cultural practices, and chemical treatments7,8. In this respect, BCA is a sustainable practice for crop disease management since it is non-toxic and environmentally friendly9,10. Several BCA’s effects against G. boninense are shown to be promising. These include the ascomycete fungi such as Trichoderma spp.11,12,13 and Hendersonia sp.14, the bacteria Pseudomonas fluorescens and Bacillus sp.7,15, several rhizospheric and endophytic bacteria such as Pseudomonas spp. and Burkholderia spp.16,17, as well as the actinomycetes Streptomyces sp.18. Some of the criteria used for selection of a BCA is mainly based on their ability to compete with the pathogens for nutrients and space, parasitism, as well as the production of secondary metabolites, volatile organic compounds, and enzymes19.
However, the genetic variability of G. boninense due to basidiospore outcrossing has contributed to variability in the current BCA’s tolerance levels20,21. Consequently, there is a need to identify more BCA candidates to overcome this problem. The use of fungi from the order Polyporales, or also known as polypore fungi, which are distinguished by the formation of large fruiting bodies with pores or tubes on the underside, has been least explored to evaluate their potential as BCAs against G. boninense. In Malaysia, Naidu et al. first reported the in vitro inhibition of G. boninense using polypore fungi that is naturally found on oil palm trunks, namely Pycnoporus sanguineus, Trametes lactinea, and Grammothele fuligo22.
Due to the scarcity of research on polypore fungi as BCA against G. boninense, this study looked into more potential isolates, particularly those available in the rich Borneo rainforest that have not been reported before. The potential of Bornean polypore fungi as BCAs was thus evaluated in this study. The pathogenicity of the polypore fungi was first tested, based on in planta fungi inoculation of oil palm seedlings to identify the non-pathogenic polypores. This was followed by evaluation of the in vitro antagonistic effects of some selected non-pathogenic polypore fungi against G. boninense, based on dual culture and volatile organic compounds assays.
Results
Pathogenicity of polypore fungi
To distinguish between the pathogenic and non-pathogenic fungi, disease signs and symptoms in the tested oil palm seedlings, indicating successful infection of the polypore fungi were observed and recorded at week four post inoculation. The results are shown in Fig. 1. Among the 21 polypore fungi isolates tested, 12 of them caused infection with typical disease signs and symptoms, including the appearance of chlorotic leaves, necrotic leaves, fungal mass on the oil palm seedling bole, and necrotic roots after four weeks of incubation. The expressed disease signs and symptoms were similar in all the infected seedlings, regardless of the polypore fungi isolates tested. Uninoculated seedlings, seedlings inoculated with two non-pathogenic Ganoderma lucidium isolates and six other polypore fungi isolates remained symptomless throughout the experiment.
Disease signs and symptoms in oil palm seedlings at four weeks after the inoculation of polypore fungi, in planta. (a) Healthy or symptomless seedling. (b) Chlorotic (i) and necrotic (ii) leaves. (c) Fungal mass on an infected seedling (arrow). (d) Decayed primary roots (arrow). (e) Leaves of healthy (i) and infected (ii) seedlings. (f) Roots of healthy (i) and infected (ii) seedlings.
Table 1 depicts the degree of infection by G. boninense in oil palm seedlings based on disease incidence, disease severity, percentage of symptomatic leaves, and percentage of infected primary roots. Oil palm seedlings inoculated with the polypore fungi G. lucidum (GL01 and GL02), RDC06, RDC24, SRP11, SRP12, SRP17, and SRP18 showed no disease incidence and were healthy, similar to the uninoculated negative control. These fungi isolates were deemed non-pathogenic and were chosen for subsequent in vitro antagonistic assays.
The positive control (G4), SRP01, and SRP14 are highly pathogenic, with 80% to 100% disease incidence, 60% to 64% disease severity, 54% to 64% symptomatic leaves, and 58.3% to 78.3% infected primary roots in the tested oil palm seedlings. Meanwhile, RDC14, RDC15, RDC26, SRP06, SRP23, and SRP29 were moderately pathogenic, with disease incidence ranging from 60 to 80%, disease severity ranging from 15 to 20%, symptomatic primary leaves ranging from 14 to 46%, and infected primary roots ranging from 7.3% to 53.3%. Oil palm seedlings inoculated with RDC07, RDC30, SRP02, and SRP08 exhibited the least infection. The disease incidence, disease severity, symptomatic leaves, and infected primary roots for these isolates were 20–40%, 10–20%, 5–18%, and 5.0–9.0%, respectively. Further, Pearson’s correlation analysis revealed that all dependent variables measured were positively correlated between each other, where they recorded high coefficients and, r values ranging from 0.80 to 0.97 at significance level of p < 0.001 (Table 2).
In vitro antagonistic assays
The antagonistic effect exerted by each non-pathogenic polypore fungi against G. boninense was evaluated through in vitro dual culture and VOCs dual plate assays. Table 3 shows the in vitro dual culture and VOCs dual plate assays of the eight selected non-pathogenic polypore fungi tested against G. boninense (G4). Based on their dual culture assay mean values, GL01 and SRP12 were weak antagonists (21–40%), while GL02, RDC06, and SRP02 were moderate antagonists (41–60%), and RDC24, SRP11, SRP17, and SRP18 were strong antagonists (61–80%). In the VOCs dual plate assay, RDC24 was a very weak antagonist (1–20%), while GL02, RDC06, SRP02, and SRP12 were weak antagonists (21–40%), and GL01, SRP11, SRP17, and SRP18 were moderate antagonists (41–60%).
The ability of the fungi to inhibit G. boninense in the dual culture and VOCs dual plate assays were not significantly correlated (p = 0.38, r = 0.33). Also, SRP11 and SRP18 recorded the highest PIRG in the dual culture assay at 67.7% and 72.7%, respectively, followed by SRP17 (67.3%). Similarly, SRP11, SRP17, and SRP18 recorded the highest PIDG in the VOCs dual plate assay at 43.2%, 51.6%, and 52.1%, respectively. Therefore, the three isolates (SRP11, SRP17, and SRP18) were selected for further investigation as potential candidates of BCAs against G. boninense in oil palm (Fig. 2). Based on the ITS sequences, the isolates of SRP11, SRP17, and SRP18 were identified as Fomes sp., Trametes elegans, and Trametes lactinea, respectively, with 99 – 100% homology with the deduced nucleotide fragment sequences searched using BLAST (Table 4).
Discussion
Typical Ganoderma infection was observed on the oil palm seedlings. The infection was initiated at the root since the roots and inoculum source were in direct contact. The infection later progressed to the stem bole, mainly through the inner thin-walled cortex. Then, foliar symptoms (chlorosis and necrosis) appeared as a result of the damaged internal stem bole or disruption of the xylem and phloem resulting in the water and nutrients required for the seedlings not being sustained, which caused progressive desiccation of the leaves from the oldest to the youngest. The infected seedlings eventually died, either with or without visible fungal masses on the seedlings above ground23,24. Furthermore, the in planta infection of oil palm seedlings in this study adopted from Purnamasari et al. showed similar disease progression over four weeks25, compared with those infected using the technique of placing rubber wood block with Ganoderma as inoculum on older oil palm seedlings, i.e. 3-months-old, and data collection carried out over six months23,24,26.
The different levels of aggressiveness of the polypore fungi tested could be related to the modes of nutrition acquisition strategies during fungal pathogen infection on the plants, which have traditionally been classified into biotrophic and necrotrophic types of parasitism27. The highly pathogenic isolates identified in this study, SRP01 and SRP14, as well as the positive control G. boninense (G4), were necrotrophs, which are facultative parasites that derive energy from a living host, kill the host's cells, and then live saprophytically on the dead remains28. According to Idris et al.29 and Castillo et al.30, three species of pathogenic Ganoderma, namely, G. boninense, G. zonatum, and G. miniatocinctum were associated with BSR in oil palm. Other species, such as G. tornatum, G. applanatum, G. lucidum, G. pfeifferi, and G. philippi, were not pathogenic31. Meanwhile, the least infection in the isolates RDC07, RDC30, SRP02, and SRP08 could be related to biotrophic facultative saprophytic parasitism, where the fungi derive energy from living cells, have very complex nutrient requirements, and do not kill the host plants rapidly28,32.
The polypores, RDC24, SRP11, SRP17, and SRP18 in this study demonstrated strong antagonistic activity against G. boninense (G4) based on the dual culture assay, with a PIRG value of 61.2% to 72.7%. The findings in this study are similar to that reported by Naidu et al., where the in vitro PIRG value of G. boninense using the same assay was between 70 and 80%22. The fungi Pycnoporus sanguineus, Trametes lactinea, and Grammothele fuligo inhibited the in vitro growth of G. boninense by 84%, 82%, and 81%, respectively. Furthermore, another study by Naidu et al. also reported that in vitro antagonism of G. boninense using the same assay was between 73 and 85%, where Neonothopanus nambi exhibited high antagonism33. In general, the inhibition of G. boninense could be due to the predominance of BCAs against the pathogen due to competition for the available nutrients and space, parasitism, the secretion of antibiotics, or the production of secondary and volatile metabolites, and enzymes7,19,34. Non-volatile metabolites (e.g., alkaloids, flavonoids and fatty acids), and volatile metabolites (e.g., aromatic metabolites, terpenes, polyketides, butenolides and pyrones) are among the metabolites that have antifungal activity against fungi35,36. These metabolites may inhibit ergosterol synthesis (the main fungal sterol) and macromolecular synthesis, and be toxic to phytopathogens37. In addition, hydrolytic enzymes such as the chitinases produced by BCAs are able to degrade the fungal cell wall of phytopathogens, which further increases the permeability of the cell wall to subsequent entry of antifungal metabolites. Furthermore, several proteases from BCAs have been reported to act on the phytopathogens’ enzymes and impair their functions19. Several studies reported that the secondary metabolites released by Trametes spp. showed antifungal properties with inhibitory effects on complex phytopathogenic fungi such as G. boninense38,39. Moreover, it was reported that the fruiting bodies of Trametes spp. contained phenolic and flavonoid compounds and other chemicals, such as saponin, tannin, and alkaloid, giving them antifungal properties39,40.
Although the potential of Trametes lactinea as a BCA to suppress G. boninense in oil palm has been previously reported22,29, there is still a lack of information available on the role of Trametes species as BCAs against crop diseases. In particular, Trametes versicolor was the most dominant species of this genus in controlling the tomato pathogens Clavibacter michiganensis, Ralstonia solanacearum, and Leveillula taurica41,42 (Table 5). However, the role of T. elegans and Formes sp. as BCAs in controlling G. boninense or other phytopathogens remains unknown.
The Bornean non-pathogenic polypore fungi discovered in this study need to be further characterized, such as by evaluating their metabolite production using liquid chromatography-mass spectrometry (LC–MS) and gas chromatography-mass spectrometry (GC–MS), for better understanding of their roles in exerting antagonism towards G. boninense. Furthermore, in planta suppression of G. boninense infection utilizing the possible antagonists discovered, either at seedling, immature, or mature stages of oil palm, will require longer-term observation and data collection to corroborate the findings.
Materials and methods
Pathogenicity of polypore fungi
A total of 150 germinated oil palm seeds (a cross between Deli dura and AVROS pisifera) were acquired from Sawit Kinabalu Balung, Tawau, Sabah, Malaysia (4.2667° N, 117.9631° E), a commercially certified oil palm seed producer. The germinated oil palm seeds were sown in three planting pot trays (50 pots per tray) containing topsoil. The seedlings were grown in a rain-shelter facility at the Faculty of Sustainable Agriculture of Universiti Malaysia Sabah (5.9300° N, 118.0112° E) for three months, with standard nursery management practices43. These seedlings were used for the pathogenicity experiment.
The pathogenicity of 21 polypore fungi initially isolated by Darwana et al.44 was used in this study, to evaluate whether they were pathogenic or non-pathogenic towards oil palm. The fungi were isolated from the basidiocarp using potato dextrose agar (PDA) containing 50 mg L−1 streptomycin to prevent the growth of bacteria45. The pure cultures of the fungi were confirmed as dikaryotic basidiomycetes based on the presence of hyphal septa and clamp connections under microscopic observation. The fungi used in this study were obtained from its stock culture on PDA slant stored in 4 °C temperature.
The positive control comprised of G. boninense (G4) isolated from a BSR-infected oil palm, while two G. lucidum isolates (GL01 and GL02) served as the non-pathogenic internal control. The taxonomic identity of G4, GL01, and GL02 had been previously verified based on their genomic DNA fragment sequences (Supplementary Appendix S1). Other polypore fungi samples were collected from the Rainforest Discovery Centre (RDC; 5.8746° N, 117.9436° E) and Sandakan Rainforest Park (SRP; 5.8511° N, 118.0642° E) in Sandakan, Sabah, Malaysia. Samples were denoted by their local origin, i.e., RDC or SPC, followed by sample number.
Fungal inoculums preparation and oil palm seedling inoculation were prepared according to the method of Purnamasari et al., with minor modifications25. Specifically, a seven-day-old active mycelial plug (10 mm in diameter) was cultured in an Erlenmeyer flask containing 150 mL of potato dextrose broth (PDB) and incubated at 28 °C for five days on a shaking incubator at 150 rpm. The mycelia were filtered and transferred into a beaker containing 200 mL of sterile distilled water and 0.002% Tween 20. The mycelia was then blended using a 70% ethanol-sanitised handheld blender (Panasonic MX-SS40) for three minutes. The concentration of mycelia was adjusted to 105 fragments mL−1 using a hemocytometer.
Oil palm seedlings were carefully removed from the pot tray, and excessive soil was loosened from the roots before soaking in the fungi inoculum for 30 min. Uninoculated seedlings soaked in sterile distilled water served as the control. All seedlings were transplanted into polybags (15 cm × 30 cm) containing 600 g of sterilised topsoil with five replications per treatment, yielding 110 experimental units. They were arranged based on a completely randomised design (CRD) in an environmentally regulated laboratory at 25–28 °C temperature, 70–80% relative humidity, and sufficient sunlight. The seedlings were watered twice daily with sterile distilled water to maintain soil moisture.
The presence of the pathogen (disease sign) and disease symptoms were recorded four weeks post inoculation. These disease signs and symptoms included disease incidence, disease severity, the total number of leaves, the number of symptomatic leaves, the total number of primary roots, and the number of infected primary roots23. The visually observable symptoms of infected seedlings was based on numerical values of disease class ranging from 0 to 4 (Table 6)46. The numerical values were transformed to a percentage of disease severity using Eq. (1). The procedures involving plant samples were performed in accordance with the relevant guidelines and regulations, including autoclaving the samples to eliminate all possible biological contamination before disposal of the samples.
In vitro antagonistic dual culture assays
The antagonistic effect of selected non-pathogenic polypore fungi against G. boninense was evaluated using the dual culture assay of Rahman et al.47. Mycelia plugs (8 mm in diameter) of the potential antagonist and pathogen (G4) were inoculated 20 mm away from the edge of a Petri dish containing PDA (90 mm diameter) on opposite sides. A PDA plate without an antagonist served as the control. The experiment was performed with three replications, arranged in a CRD, incubated for seven days, at 28 °C, and in darkness. The percentage inhibition of radial growth (PIRG) was calculated using Eq. (2)48.
where, R1 is the colony radius of G. boninense (G4) isolates in the control plate and R2 is the colony radius of G. boninense (G4) isolate in the dual culture assay. The inhibition zone formed between the colonies was also observed. The antagonistic effect of each isolate against the growth of the G. boninense (G4) was classified as very weak (1–20%), weak (21–40%), moderate (41–60%), strong (61–80%), and very strong (81–100%) based on their PIRG values.
In vitro antagonistic volatile organic compounds (VOCs) dual plate assays
An assay of VOCs was performed to evaluate the inhibitory potential of the non-pathogenic polypore fungi against G. boninense (G4) via the production of volatile inhibitory organic compounds49. The dual plate assay was performed according to Rajani et al.50. A mycelia plug (8 mm in diameter) of the potential antagonist was inoculated at the centre of a Petri dish containing PDA (9 cm diameter), incubated for seven days, at 28 °C, and in darkness. Then, the similar-sized mycelial plug of the pathogen, G. boninense (G4), was inoculated onto another PDA plate placed inversely over the PDA plate containing the seven-day-old antagonist, and sealed with parafilm. The VOCs from the antagonist were allowed to fumigate the pathogen. Plates with G. boninense without antagonists served as controls. The setup of the experiment is shown in Fig. 3, and they were arranged in CRD with three replications. The percentage inhibition of diameter growth (PIDG) was calculated using Eq. (3)51.
where, D1 is the colony diameter of G4 isolate in the control plate, and D2 is the colony diameter of G4 isolate exposed to the antagonist colony. The same inhibition classifications as that for the dual culture assay were adopted.
Statistical analysis
Analysis of variance (ANOVA) was performed, and the means were compared using Tukey’s test at a significance level of 0.05. The relationships between the variables were evaluated using Pearson’s correlation analysis. Prior to the analysis, the statistical methods were validated in accordance with Zar52. All statistical analysis was performed using the Statistical Analysis System software (SAS version 9.4, North Carolina State University, USA).
Molecular identification of the potential biological control agents
The genomic DNA (gDNA) of the potential BCAs was extracted from their pure cultures using a commercial kit (Norgen Biotek Corp., Canada), following the manufacturer’s protocol. The fungal internal transcribed spacer (ITS) gene was amplified using the polymerase chain reaction (PCR) with forward universal primer ITS1 (5′-TCCGTAGGTGAACCTGCGG-3′) flanking 5′-M13F (5′-GTAAAACGACGGCCAGT-3′), and reverse universal primer ITS4 (5′-TCCTCCGCTTATTGATATGC-3′) flanking 5′-M13R-pUC (5′-CAGGAAACAGCTATGAC-3′)53. The PCR amplifications were carried out in a 25 μL total reaction volume containing 1 μL gDNA, 0.5 pmol of each primer, deoxynucleotides triphosphates (dNTPs, 200 μM each), a 0.5 U DNA polymerase, PCR buffer, and water. Amplification was performed with an initial denaturation step (98 °C for 2 min), followed by 25 cycles of annealing and extension (98 °C for 15 s; 60 °C for 30 s; 72 °C for 30 s), and a final extension (72 °C for 10 min). The PCR products (1 μL) were run on 1% TAE agarose (agarose with a buffer solution containing a mixture of Tris base, acetic acid and EDTA) at 100 V for 60 min, which yielded 600 to 650 base pairs were purified using standard methods54. Sequencing of the purified PCR products was performed using a BigDye® Terminator v3.1 Cycle Sequencing Kit (Applied Biosystems, USA). The sequence was used to find the homologous sequence via the basic local alignment search tools (BLAST) in the National Center for Biotechnology Information (NCBI) website (https://www.ncbi.nlm.nih.gov/).
Conclusion
Among the 21 polypore fungi isolates tested, eight isolates (GL01, GL02, RDC06, RDC24, SRP11, SRP12, SRP17, and SRP18) were non-pathogenic to oil palm seedlings. The seedlings appeared symptomless and similar to the uninoculated control. In vitro, antagonistic assays against G. boninense revealed that the PIRG value for the dual culture assay of SRP11, SRP17, and SRP18 were 69.7%, 67.3%, and 72.7%, respectively. Meanwhile, the PIDG value for the VOCs dual plate assay of SRP11, SRP17, and SRP18 were 43.2%, 51.6%, and 52.1%, respectively. This study successfully identified three polypore fungi; Fomes sp. (SRP11), T. elegans (SRP17) and T. lactinea (SRP18) as potential fungal BCAs against G. boninense. However, additional analysis, characterization, and validation assays are required to further justify and confirm their potential as efficient BCAs against G. boninense.
Data availability
All data generated or analyzed during this study are included in this published article and its supplementary information files.
References
United States Department of Agriculture (USDA). Oilseeds: World markets and Trade (November 2021) 2021 (Foreign Agricultural Service, UDSA, 2021).
Rees, R. W., Flood, J., Hasan, Y., Wills, M. A. & Cooper, R. M. Ganoderma boninense basidiospores in oil palm plantations: Evaluation of their possible role in stem rots of Elaeis guineensis. Plant Pathol. 61, 567–578. https://doi.org/10.1111/j.1365-3059.2011.02533.x (2012).
Rakib, M. R. M., Bong, C. F. J., Khairulmazmi, A. & Idris, A. S. Genetic and morphological diversity of Ganoderma species isolated from infected oil palms (Elaeis guineensis). Int. J. Agric. Biol. 16, 691–699 (2014).
Hushiarian, R., Yusof, N. A. & Dutse, S. W. Detection and control of Ganoderma boninense: strategies and perspectives. Springerplus 2, 555. https://doi.org/10.1186/2193-1801-2-555 (2013).
Alam, A. S. A. F., Er, A. C. & Begum, H. Malaysian oil palm industry: Prospect and problem. J. Food. Agric. Environ. 13, 143–148 (2015).
Assis, K., Chong, K. P., Idris, A. S., Darmesah, G. & Ho, C. M. Estimating the yield loss of oil palm due to Ganoderma basal stem rot disease by using Bayesian Model Averaging. J. Oil Palm Res. 3, 46–55. https://doi.org/10.21894/jopr.2020.0061 (2020).
Susanto, A., Sudharto, P. S. & Purba, R. Enhancing biological control of basal stem rot disease (Ganoderma boninense) in oil palm plantations. Mycopathologia 159, 153–157. https://doi.org/10.1007/s11046-004-4438-0 (2005).
Lim, K. H., Lim, S. S., Parish, F. & Suharto, R. RSPO Manual on Best Management Practices (BMPs) for Existing Oil Palm Cultivation on Peat (Roundtable Sustainable Palm Oil, 2013).
Contreras-Cornejo, H. A., Macías-Rodríguez, L., Del-Val, E. & Larsen, J. Interactions of Trichoderma with plants, insects, and plant pathogen microorganisms: Chemical and molecular bases. In Co-Evolution of Secondary Metabolites (eds Mérillon, J. M. & Ramawat, K. G.) 263–290 (Springer International Publishing, 2020).
Tariq-Javeed, M., Farooq, T., Al-Hazmi, A. S., Hussain, M. D. & Rehman, A. U. Role of Trichoderma as a biocontrol agent (BCA) of phytoparasitic nematodes and plant growth inducer. J. Invertebr. Pathol. 183, 107626. https://doi.org/10.1016/j.jip.2021.107626 (2021).
Shamala, S., Faridah, A., Zainal, A. M. A. & Umi, K. Y. Efficacy of single and mixed treatments of Trichodrma harzianum as biocontrol agents of Ganoderma basal stem rot in oil palm. J. Oil Palm Res. 20, 470–483 (2008).
Musa, H., Hassan, M. A., Isyaku, M. S., Halidu, J. & Suleiman, A. S. Antagonistic potential of Trichoderma species against Ganoderma disease of oil palm. Nig. J. Agric. Food Environ. 13, 60–67 (2017).
Muniroh, M. S., Nusaibah, S. A., Vadamalai, G. & Siddique, Y. Proficiency of biocontrol agents as plant growth promoters and hydrolytic enzyme producers in Ganoderma boninense infected oil palm seedlings. Curr. Plant Biol. 20, 100116. https://doi.org/10.1016/j.cpb.2019.100116 (2019).
Munthe, K. P. S. M. & Dahang, D. Hosting of Hendersonia against Ganoderma (Ganoderma boniense) disease in oil palm (Elaeis guineensis Jacq.). Int. J. Multidiscip. Res. Dev. 5, 46–50. https://doi.org/10.22271/ijmrd (2018).
Chin, C. F. S. et al. Novel multifunctional plant growth–promoting bacteria in co-compost of palm oil industry waste. J. Biosci. Bioeng. 124, 506–513. https://doi.org/10.1016/j.jbiosc.2017.05.016 (2017).
Chin, C. F. S., Chyng, A. W. & Hoe, N. W. Isolation of rhizospheric and endophytic soil bacteria SPLUMS-1 and SPLUMS-2 of oil palm against Ganoderma sp. JN234427. Mal. J. Microbiol. 11, 116–120. https://doi.org/10.21161/mjm.12214 (2015).
Nur Rashyeda, R., Maizatul, S. M., Idris, A. S., Madihah, A. Z. & Nasyaruddin, M. The potential of endophytic bacteria as a biological control agent for Ganoderma disease in oil palm. Sains Malaysiana 45, 401–409 (2016).
Lim, P. H., Gansau, J. A. & Chong, K. P. Streptomyces spp. A potential biological agent against Ganoderma boninense of basal stem rot. J. Oil Palm Res. 30, 265–275. https://doi.org/10.21894/jopr.2018.0024 (2018).
Köhl, J., Kolnaar, R. & Ravensberg, W. J. Mode of action of microbial biological control agents against plant diseases: Relevance beyond efficacy. Front. Plant Sci. 10, 845. https://doi.org/10.3389/fpls.2019.00845 (2019).
Wong, W. C. et al. Genetic diversity and gene flow amongst admixed populations of Ganoderma boninense, causal agent of basal stem rot in African oil palm (Elaeis guineensis Jacq.) in Sarawak (Malaysia), Peninsular Malaysia, and Sumatra (Indonesia). Mycologia 114, 947–963. https://doi.org/10.1080/00275514.2021.1884815 (2022).
Baharudin, I. et al. Review update on the life cycle, plant–microbe interaction, genomics, detection and control strategies of the oil palm pathogen Ganoderma boninense. Biology 11, 251. https://doi.org/10.3390/biology11020251 (2022).
Naidu, Y., Idris, A. S., Nusaibah, S. A., Norman, K. & Siddiqui, Y. In vitro screening of biocontrol and biodegradation potential of selected hymenomycetes against Ganoderma boninense and infected oil palm waste. For. Pathol. 45, 474–483. https://doi.org/10.1111/efp.12197 (2015).
Rakib, M. R. M., Bong, C. F. J., Khairulmazmi, A. & Idris, A. S. Aggressiveness of Ganoderma boninense and G. zonatum isolated from upper- and basal stem rot of oil palm (Elaeis guineensis) in Malaysia. J. Oil Palm Res. 27, 229–240 (2015).
Rees, R. W., Flood, J., Hasan, Y., Potter, U. & Cooper, R. M. Basal stem rot of oil palm (Elaeis guineensis); mode of root infection and lower stem invasion by Ganoderma boninense. Plant Pathol. 58, 982–989. https://doi.org/10.1111/j.1365-3059.2009.02100.x (2009).
Purnamasari, M. I., Agustina, D., Prihatna, C. & Suwanto, A. A rapid inoculation method for infection of Ganoderma in oil palm. Int. J. Oil Palm 1, 1–9. https://doi.org/10.35876/ijop.v1i1.1 (2018).
Naidu, Y., Siddiqui, Y., Rafii, M. Y., Saud, H. M. & Idris, A. S. Inoculation of oil palm seedlings in Malaysia with white-rot hymenomycetes: Assessment of pathogenicity and vegetative growth. Crop Protect. 110, 146–154. https://doi.org/10.1016/j.cropro.2018.02.018 (2018).
Divon, H. H. & Fluhr, R. Nutrition acquisition strategies during fungal infection of plants. FEMS Microbiol. Lett. 266, 65–74. https://doi.org/10.1111/j.1574-6968.2006.00504.x (2007).
Moore, D., Robson, G. D. & Trinci, A. P. J. 21st Century Guidebook to Fungi 2nd edn. (Cambridge University Press, 2020).
Idris, A., Ariffin, D., Swinburne, T. & Watt, T. The identity of Ganoderma species responsible for BSR disease of oil palm in Malaysia—morphological characteristics. MPOB Inf. Ser. 14, 225 (2000).
Castillo, S. Y. et al. Ganoderma zonatum is the causal agent of basal stem rot in oil palm in Colombia. J. Fungi 8, 230. https://doi.org/10.3390/jof8030230 (2022).
Chong, K. P., Dayou, J. & Alexander, A. Pathogenic nature of Ganoderma boninense and basal stem rot disease. In Detection and Control of Ganoderma boninense in Oil Palm Crop (eds Chong, K. P. et al.) 5–12 (Springer, 2017).
Doehlemann, G., Ökmen, B., Zhu, W. & Sharon, A. Plant pathogenic fungi. Microbiol. Spectrum https://doi.org/10.1128/microbiolspec.FUNK-0023-2016 (2017).
Naidu, Y., Idris, A. S., Madihah, A. Z. & Kamarudin, N. In vitro antagonistic interactions between endophytic basidiomycetes of oil palm (Elaeis guineensis) and Ganoderma boninense. J. Phytopathol. 164, 779–790. https://doi.org/10.1111/jph.12498 (2016).
Hermosa, M. R. et al. Molecular characterization and identification of biocontrol isolates of Trichoderma spp. Appl. Environ. Microbiol. 66, 1890–1898. https://doi.org/10.1128/aem.66.5.1890-1898.2000 (2000).
Ahmad, R. et al. Metabolic profile of Scytalidium parasiticum-Ganoderma boninense co-cultures revealed the alkaloids, flavonoids and fatty acids that contribute to anti-Ganoderma activity. Molecules 25, 5965. https://doi.org/10.3390/molecules25245965 (2020).
Siddiquee, S., Cheong, B. E., Taslima, K., Kausar, H. & Hasan, M. M. Separation and identification of volatile compounds from liquid cultures of Trichoderma harzianum by GC-MS using three different capillary columns. J. Chromatogr. Sci. 50, 358–367. https://doi.org/10.1093/chromsci/bms012 (2012).
Ghannoum, M. A. & Rice, L. B. Antifungal agents: mode of action, mechanisms of resistance, and correlation of these mechanisms with bacterial resistance. ASM J. Clin. Microbiol. Rev. 12, 501–517. https://doi.org/10.1128/CMR.12.4.501 (1999).
Ernesto, H. M., Marcelo, A. R., Antonio, S. M. & Catalina, R. G. Evaluation of crude extracts of Trametes versicolor (L.:Fr.) Pilát to control of phytopathogenic fungi. Int. J. Plant Res. 9, 8–13. https://doi.org/10.5923/j.plant.20190901.02 (2019).
Knežević, A. et al. Antioxidative, antifungal, cytotoxic and antineurodegenerative activity of selected Trametes species from Serbia. PLOS ONE 13, e0203064. https://doi.org/10.1371/journal.pone.0203064 (2018).
Yamaç, M. & Bilgili, F. Antimicrobial activities of fruit bodies and/or mycelial cultures of some mushroom isolates. Pharm. Biol. 44, 660–667. https://doi.org/10.1080/13880200601006897 (2006).
Orzali, L., Valente, M. T., Scala, V., Loreti, S. & Pucci, N. Antibacterial activity of essential oils and Trametes versicolor extract against Clavibacter michiganensis subsp. michiganensis and Ralstonia solanacearum for seed treatment and development of a rapid in vivo assay. Antibiotics 9, 628. https://doi.org/10.3390/antibiotics9090628 (2020).
Mendieta, E. H., Ramos, M. A., Miranda, A. S., Sánchez, D. G. & Grandos, C. R. Hexanic extracts of Trametes versicolor (L.:Fr.) Pilát to control of tomato powdery mildew. Int. J. Plant Res. 10, 11–16. https://doi.org/10.5923/j.plant.20201001.02 (2020).
Malaysian Palm Oil Board (MPOB). MPOB Code of Practice: Code of Good Nursery Practice for Oil Palm Nurseries 2nd edn. (MPOB, 2016).
Darwana, D., Rakib, M. R. M. & Jalloh, M. B. Characterization and identification of polypore fungi collected from forests in Sandakan, Sabah based on the macro- and micro-morphology. Trans. Sci. Technol. 6, 283–291 (2019).
Zhang, X., Yu, H., Huang, H. & Liu, Y. Evaluation of biological pretreatment with white rot fungi for the enzymatic hydrolysis of bamboo culms. Int. Biodeterior. Biodegrad. 60, 159–164. https://doi.org/10.1016/j.ibiod.2007.02.003 (2007).
Abdullah, F., Ilias, G. N. M., Nelson, M., Namz, I. & Umi, K. Y. Disease assessment and the efficacy of Trichoderma as a biocontrol agent of basal stem rot of oil palms. Sci. Putra 11, 31–33 (2003).
Rahman, M. A., Begum, M. F. & Alam, M. F. Screening of Trichoderma isolates as a biological control agent against Ceratocystis paradoxa causing pineapple disease of sugarcane. Mycobiology 37, 277–285. https://doi.org/10.4489/myco.2009.37.4.277 (2019).
Bivi, M. R., Farhana, M. S. N., Khairulmazmi, A. & Idris, A. S. Control of Ganoderma boninense: A causal agent of basal stem rot disease in oil palm with endophyte bacteria in vitro. Int. J. Agric. Biol. 12, 833–839 (2010).
Gotor-Vila, A. et al. Antifungal effect of volatile organic compounds produced by Bacillus amyloliquefaciens CPA-8 against fruit pathogen decays of cherry. Food Microbiol. 64, 219–225. https://doi.org/10.1016/j.fm.2017.01.006 (2017).
Rajani, P. et al. Inhibition of plant pathogenic fungi by endophytic Trichoderma spp. through mycoparasitism and volatile organic compounds. Microbiol. Res. 242, 126595. https://doi.org/10.1016/j.micres.2020.126595 (2021).
Ting, A. S. Y., Mah, S. W. & Tee, C. S. Identification of volatile metabolites from fungal endophytes with biocontrol potential towards Fusarium oxysporum F. sp. Cubense Race 4. Am. J. Agric. Biol. Sci. 5, 177–182. https://doi.org/10.3844/ajabssp.2010.177.182 (2010).
Zar, J. H. Biostatistical Analysis 5th edn. (Pearson, 2014).
Ragonezi, C. et al. Molecular approach to characterize ectomycorrhizae fungi from Mediterranean pine stands in Portugal. Braz. J. Microbiol. 44, 663–670. https://doi.org/10.1590/S1517-83822013005000035 (2013).
Ma, H. & DiFazio, S. An efficient method for purification of PCR products for sequencing. Biotechniques 44, 921–923. https://doi.org/10.2144/000112809 (2018).
Acknowledgements
The authors gratefully acknowledge Universiti Malaysia Sabah (Malaysia) for their support in providing research funding (grant number SLB0138-2017), facilities, and technical assistance. The APC was funded by Universiti Malaysia Sabah. Acknowledgments also go to Sawit Kinabalu Sdn. Bhd. (Malaysia) for providing the oil palm planting materials used in this study, and to Sabah Forestry Department (Malaysia) for permission to collect samples from the forests under its jurisdiction. Finally, the authors would also like to thank the academic editor and anonymous reviewers, whose constructive comments and suggestions significantly improved the article.
Funding
This research was funded by Universiti Malaysia Sabah (Malaysia), grant number SLB0138-2017. The funds were awarded to Mohd. Rashid Mohd. Rakib. The funders had no role in the design of the study, in the collection, analysis, or interpretation of data, in the writing of the manuscript, or in the decision to publish the results.
Author information
Authors and Affiliations
Contributions
Conceptualization, M.R.M.R., M.B.J. and D.D.; formal analysis, D.D.; funding acquisition, M.R.M.R.; investigation, D.D.; methodology, M.R.M.R. and D.D.; project administration, M.R.M.R.; resources, M.R.M.R.; supervision, M.R.M.R.; writing—original draft, D.D. and N.K.M.B.; writing—review and editing, M.R.M.R., M.B.J., C.F.S.C., N.A.B. and K.A. All authors have read and agreed to the published version of the manuscript.
Corresponding author
Ethics declarations
Competing interests
The authors declare no competing interests.
Additional information
Publisher's note
Springer Nature remains neutral with regard to jurisdictional claims in published maps and institutional affiliations.
Supplementary Information
Rights and permissions
Open Access This article is licensed under a Creative Commons Attribution 4.0 International License, which permits use, sharing, adaptation, distribution and reproduction in any medium or format, as long as you give appropriate credit to the original author(s) and the source, provide a link to the Creative Commons licence, and indicate if changes were made. The images or other third party material in this article are included in the article's Creative Commons licence, unless indicated otherwise in a credit line to the material. If material is not included in the article's Creative Commons licence and your intended use is not permitted by statutory regulation or exceeds the permitted use, you will need to obtain permission directly from the copyright holder. To view a copy of this licence, visit http://creativecommons.org/licenses/by/4.0/.
About this article
Cite this article
Darlis, D., Jalloh, M.B., Chin, C.F.S. et al. Exploring the potential of Bornean polypore fungi as biological control agents against pathogenic Ganoderma boninense causing basal stem rot in oil palm. Sci Rep 13, 10316 (2023). https://doi.org/10.1038/s41598-023-37507-0
Received:
Accepted:
Published:
DOI: https://doi.org/10.1038/s41598-023-37507-0
Comments
By submitting a comment you agree to abide by our Terms and Community Guidelines. If you find something abusive or that does not comply with our terms or guidelines please flag it as inappropriate.